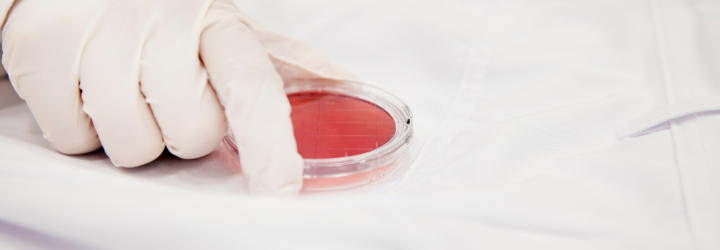

Voorkom kruisbesmetting: de rol van bedrijfskleding bij voedselveiligheid(standaarden)
In basisvoorwaardenprogramma’s voor voedselveiligheidstandaarden is het voorkomen van kruisbesmetting een belangrijk onderdeel. Om daaraan te voldoen zou écht schone bedrijfskleding niet mogen ontbreken in de voedingsindustrie.
BRC, IFS en FSSC 22000 zijn bekende standaarden in de voedingsindustrie die door de Global Food Safety Initiative (GFSI) worden erkend. Ook ISO 22000 is een wereldwijd geaccepteerde systeemnorm voor voedselveiligheid. Een van de eisen die bijvoorbeeld FSCC 22000 en ISO 22000 aan bedrijven stellen, is ‘voldoen aan het basisvoorwaardenprogramma’.